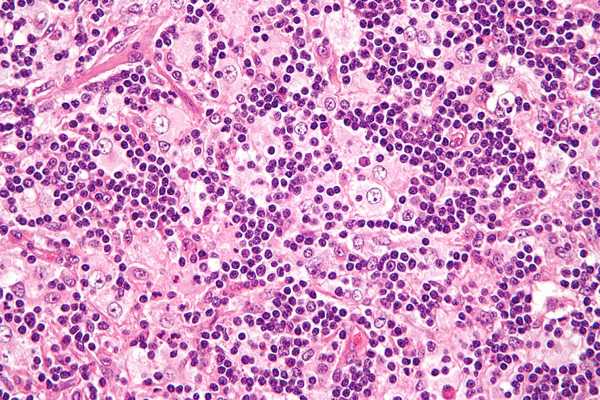
гистоциоз

Дифференциальная диагностика гистиоцитоза Х
Добавил пользователь Алексей Ф. Обновлено: 02.11.2025
ФГБОУ ВО СЗГМУ им. И.И. Мечникова Минздрава России, Санкт-Петербург; СПб ГБУЗ «ДГМКЦ ВМТ им. К.А. Раухфуса», Санкт-Петербург
ФГБОУ ВО СЗГМУ им. И.И. Мечникова Минздрава России, Санкт-Петербург ; СПб ГБУЗ «ДГМКЦ ВМТ им. К.А. Раухфуса», Санкт-Петербург
Гистиоцитозы представляют собой группу заболеваний, которые объединяет пролиферативный процесс в моноцитарно-макрофагальной системе с накоплением в очагах поражения патологических гистиоцитов и формированием специфических гранулем.
Возможна иммунопатологическая и опухолевая природа заболевания. В пользу иммунопатологической природы гистиоцитоза свидетельствуют высокая частота спонтанных ремиссий, низкая летальность и отсутствие хромосомных аномалий в клетках из очагов поражения, в пользу опухолевой природы — клональный характер пролиферации клеток Лангерганса в очагах поражения.
Клинические проявления гистиоцитоза весьма разнообразны, что определяет трудность диагностики. В патологический процесс могут вовлекаться различные органы и ткани: кожа, лимфатические узлы, наружное и среднее ухо, плоские кости, костный мозг, печень, селезенка, легкие, эндокринные железы, желудочно-кишечный тракт, головной мозг.
В статье представлен клинический случай гистиоцитоза, диагностированный у ребенка 1 мес. 3 нед., клинические проявления которого маскировались под симптомы наружного диффузного отита.
Описание данного клинического случая преследует цель обратить внимание на особенности течения рецидивирующих наружных и средних отитов у грудных детей, т. к. за маской данных заболеваний может скрываться гистиоцитоз.
Ключевые слова: наружный и средний диффузный отит, дети грудного возраста, гистиоцитоз, компьютерная томография.
Clinical observation of histiocytosis, proceeding under the mask of an acute otitis externa, in a child of 1 month 3 weeks
M.V. Molchanova 1,2 , S.I. Alexeenko 1,2 , S.A. Artyushkin 1
1 Mechnikov Northwestern State Medical University, Saint Petersburg
2 Raukhfus Children City Multi-Profile Clinical Center of High Medical Technologies, Saint Petersburg
A histiocytosis is a group of diseases that combine the proliferative process in the monocyte-macrophage system with the accumulation of pathological histiocytes in the lesions and a formation of specific granulomas.
There is a possibility of an immunopathological and tumor nature of the disease. A high incidence of spontaneous remission, low mortality and an absence of chromosomal abnormalities in cells from lesions are in favor of the immunopathological nature of histiocytosis. In favor of the tumor nature — the clonal nature of the Langerhans cells proliferation in the lesions.
Clinical manifestations of histiocytosis are very diverse, which determines the difficulty of diagnosis. Various organs and tissues can be involved in the pathological process: skin, lymph nodes, external and middle ear, flat bones, bone marrow, liver, spleen, lungs, endocrine glands, gastrointestinal tract, brain.
The article presents a clinical case of histiocytosis diagnosed in a child of 1 month 3 weeks, the clinical manifestations of which were masked under the symptoms of an acute otitis externa.
The description of this clinical case is intended to draw attention to the peculiarities of the course of recurrent otitis externa and otitis media in infants, as the “mask” of these diseases may be histiocytosis.
Key words: acute otitis externa and otitis media, infants, histiocytosis, computerized tomography.
For citation: Molchanova M.V., Alexeenko S.I., Artyushkin S.A. Clinical observation of histiocytosis, proceeding under the mask of an acute otitis externa, in a child of 1 month 3 weeks // RMJ. 2018. № 10(II). P. 102-104.
Для цитирования: Клиническое наблюдение гистиоцитоза у ребенка 1 месяца 3 недель, протекавшего под маской наружного диффузного отита. РМЖ. 2018;10(II):102-104.
В статье представлен клинический случай гистиоцитоза, диагностированный у ребенка 1 мес. 3 нед., клинические проявления которого маскировались под симптомы наружного диффузного отита.
Введение
Гистиоцитозы представляют собой группу заболеваний, разнообразных по клиническим проявлениям и прогнозу, которые объединяет пролиферативный процесс в моноцитарно-макрофагальной системе с накоплением в очагах поражения патологических гистиоцитов и формированием специфических гранулем 4. Современная классификация гистиоцитозов включает 3 нозологические формы: гистиоцитоз из клеток Лангерганса, злокачественный гистиоцитоз и вирус-ассоциированный гемофагоцитарный синдром [2, 5].
Гистиоцитоз из клеток Лангерганса — крайне редкое заболевание: в детском возрасте встречаются 3-4 случая на 1 млн населения, у взрослых — 1 случай на 560 000 населения 8.
Этиология и патогенез гистиоцитоза до конца не изучены [2, 6, 9]. Возможна иммунопатологическая и опухолевая природа заболевания. В пользу иммунопатологической природы гистиоцитоза свидетельствуют высокая частота спонтанных ремиссий, низкая летальность (у детей — 15%, у взрослых — 3%) и отсутствие хромосомных аномалий в клетках из очагов поражения. В пользу опухолевой природы говорит клональный характер пролиферации клеток Лангерганса в очагах поражения [10].
Клинические проявления гистиоцитоза весьма разнообразны, что определяет трудность диагностики. В патологический процесс могут вовлекаться различные органы и ткани: кожа, лимфатические узлы, наружное и среднее ухо, плоские кости, костный мозг, печень, селезенка, легкие, эндокринные железы, желудочно-кишечный тракт, головной мозг [2, 6, 11].
Среди ЛОР-органов наиболее часто поражаются наружное и среднее ухо с кровянисто-гнойными выделениями из наружного слухового прохода, имитируя таким образом наружный и средний гнойный отит.
Верификация диагноза проводится на основании биопсии пораженных очагов с последующим гистологическим и иммуногистохимическим исследованиями материала [2].
Клинический случай гистиоцитоза
Вашему вниманию предлагается случай своевременно диагностированного гистиоцитоза у ребенка грудного возраста.
Девочка Г., 1 мес. 3 нед., поступила в ЛОР-отделение СПб ГБУЗ «ДГМКЦ ВМТ им. К.А. Раухфуса» в экстренном порядке с жалобами на геморрагические выделения из правого уха.
Из анамнеза заболевания известно, что за 2 нед. до поступления на фоне полного здоровья родители заметили геморрагические выделения из правого уха у девочки в небольшом количестве. Факт травмы родители отрицали. К ЛОР-врачу амбулаторно не обращались. Появившиеся выделения из правого уха повторно побудили родителей обратиться в дежурный ЛОР-стационар.
Из анамнеза жизни известно, что девочка от первой беременности, первых срочных родов. Беременность протекала без особенностей. При рождении: масса тела — 3650 г, рост — 53 см, закричала сразу, оценка по шкале Апгар — 8/8 баллов. Девочка находилась на грудном вскармливании, отмечались достаточные весовые прибавки. Проходила регулярные плановые осмотры в декретированные сроки у педиатра и специалистов в поликлинике по месту жительства. Девочка наблюдается у хирурга, онколога по месту жительства по поводу образования боковой поверхности грудной клетки слева (лимфангиома?).
При поступлении: ребенок в сознании, активен, сон не нарушен, аппетит не снижен. Температура тела 36,5 °С. Общий соматический статус без отклонений от возрастной нормы.
Проведена оценка ЛОР-статуса. Риноскопия: носовое дыхание удовлетворительное. Слизистая носа розовая, носовые раковины обычные, отделяемого нет. Фарингоскопия: слизистая глотки розовая, налетов не обнаружено.

Выполнена отоскопия. AD: заушная область не изменена. Кожа наружного слухового прохода незначительно гиперемирована, инфильтрирована. В наружном слуховом проходе отмечается гнойно-геморрагическое отделяемое. На задневерхней стенке наружного слухового прохода на границе с барабанной перепонкой визуализируется образование розового цвета, однородное, с четкими контурами, размер 7×5,5 мм, при дотрагивании кровоточит. Барабанная перепонка обозрима не полностью, серая. AS: заушная область не изменена. Наружный слуховой проход широкий, свободный. Барабанная перепонка серая, контуры четкие.
Ребенок госпитализирован в ЛОР-отделение, проведено дообследование: клинический анализ крови, общий анализ мочи, копрограмма, бактериологическое исследование патологического отделяемого из правого уха, УЗИ органов брюшной полости, желудка, биохимический анализ крови, ЭКГ, консультация педиатра.
После угасания острого воспалительного процесса наружного слухового прохода справа выполнена компьютерная томография височных костей с внутривенным введением контрастного вещества.
В клиническом анализе крови отмечались признаки анемии легкой степени тяжести (эритроциты 3,09×10 12 , гемоглобин 100 г/л).
В общем анализе мочи, копрограмме, УЗИ органов брюшной полости, желудка патологии не выявлено.
В результате бактериологического исследования отделяемого из наружного слухового прохода справа выделен Staphylococcus aureus, чувствительный к амоксициллину в комбинации с клавулановой кислотой, цефотаксиму, цефтриаксону.
ЭКГ: синусовый ритм с ЧСС 138 уд./мин, нормальное положение электрической оси сердца. Поворот против часовой стрелки (R1, V1-V6); неполная блокада правой ножки пучка Гиса.
Девочка консультирована педиатром. Диагноз: Образование боковой поверхности грудной клетки слева (лимфангиома?). Анемия легкой степени тяжести.
Проведена консервативная терапия: системная антибактериальная терапия (цефтриаксон по 400 мг 1 р./сут в/м 10 дней); антигистаминная терапия (диметинден (капли) по 3 капли 3 р./сут внутрь); интраназально вводился вазоконстриктор (оксиметазолин 0,01% по 1 капле 2 р./сут); местный антибактериальный препарат (в правое ухо: рифамицин по 3 капли 3 р./сут 10 дней).
На фоне проводимой терапии воспалительные явления стихли, однако при отоскопии сохранялось образование на задневерхней стенке наружного слухового прохода справа.
С целью уточнения распространенности процесса назначена компьютерная томография височных костей с внутривенным введением контрастного вещества.
По данным компьютерной томографии височных костей, выполненной по стандартной программе до и после внутривенного введения контрастного вещества, на задней стенке наружного слухового прохода справа определяется мягкотканное образование однородной структуры, овальной формы с четкими контурами, размером 7×5,5 мм. Образование прилежит к барабанной перепонке, несколько смещает ее внутрь, умеренно накапливает контрастный препарат. Просвет наружного слухового прохода в данной области сужен до 1 мм. Костных деструктивных изменений не выявлено. Антрум и барабанные полости с обеих сторон пневматизированы. Слуховые косточки прослеживаются четко. Улитки без особенностей (рис. 1).
В условиях операционной под внутривенным наркозом при отомикроскопическом контроле удалено образование наружного слухового прохода справа. Материал направлен на гистологическое исследование.
По результатам патоморфологического исследования: гистологическая картина лангергансоклеточного гистиоцитоза.
Девочка консультирована детским онкологом. Рекомендован пересмотр блоков и стекол с выполнением иммуногистохимического исследования материала в НМИЦ ДГОИ им. Д. Рогачева.
Катамнез: по результатам гистологического и иммуногистохимического исследования в НМИЦ ДГОИ им. Д. Рогачева диагноз подтвержден. После выписки из ЛОР-отделения ДГМКЦ ВМТ им. К.А. Раухфуса девочка прошла обследование у онколога, другие очаги не выявлены. Системная терапия онкологом не назначалась. В течение года 1 раз в 3 мес. консультируется онкологом, оториноларингологом, ребенку проводится отомикроскопия — отмечается стойкая ремиссия.
Заключение
Описание данного клинического случая преследует цель обратить внимание на особенности течения рецидивирующих наружных и средних отитов у грудных детей, т. к. за маской данных заболеваний может скрываться гистиоцитоз.
Список литературы Свернуть Развернуть
Контент доступен под лицензией Creative Commons «Attribution» («Атрибуция») 4.0 Всемирная.
Эозинофильная гранулема ( Болезнь Таратынова )
Эозинофильная гранулема - это очаговая форма гистиоцитоза из клеток Лангерганса, которая проявляется опухолеподобными очагами в костях. Основной причиной заболевания называют генетические мутации, которые запускают аномальную пролиферацию клеток. Проявления патологии зависят от локализации опухоли: боли в костях, патологические переломы, выпадение зубов, экзофтальм и нарушения зрения. Для диагностики гранулемы назначают рентгенографию костей, исследования крови, гистологический анализ костных очагов. Лечение проводится хирургическим способом (кюретаж, резекция), по показаниям дополняется фармакотерапией и лучевой терапией.
МКБ-10

Общие сведения
Эозинофильная гранулема встречается с частотой 3-5 случаев на 1 млн. населения, в основном в подростковом и юношеском возрасте. Мужчины болеют в 2 раза чаще женщин. Случаи заболевания среди пациентов среднего и пожилого возраста встречаются крайне редко. Этот вид доброкачественной опухоли составляет менее 1% всех объемных новообразований костной ткани и до 80% случаев гистиоцитоза. В отечественной литературе гранулему иногда называют болезнью Таратынова по имени российского патологоанатома, который впервые описал нетипичные очаги поражения в костной ткани.

Причины
Несмотря на многочисленные научные изыскания, до сих пор не удалось установить этиологическую структуру эозинофильной гранулемы и других вариантов гистиоцитоза. Большое значение придают генетическим мутациям. Чаще всего встречается врожденная аномалия гена BRAF, который отвечает за деление и выживание разных типов клеток. Второй по частоте является мутация гена MAP2K1, который кодирует белки сигнального пути и участвует в процессе клеточной пролиферации.
Патогенез
Образование очага эозинофильной гранулемы связывают с пролиферацией клеток Лангерганса, которые имеют костномозговое происхождение. Они относятся к компонентам иммунной системы и участвуют в первом этапе защиты: выполняют антигенпредставляющую функцию. При гистиоцитозе клетки начинают активное деление в костной ткани, где образуют опухолевые очаги. Этому способствует повышенная экспрессия факторов пролиферации и ингибиторов апоптоза.
Гистиоциты и эозинофилы патологического происхождения, которые составляют гранулему, находятся на разных стадиях дифференцировки. Они умеренно пролиферируют, плохо восприимчивы к физиологическому апоптозу, из-за чего длительно персистируют в очаге. Такие особенности в сочетании моноклональностью клеток и избыточной активацией Т-супрессоров позволяют рассматривать очаговый гистиоцитоз как неопластический процесс.

Симптомы эозинофильной гранулемы
Небольшие по размеру опухоли, которые расположены в костях скелета тела, длительное время протекают бессимптомно. Изредка пациенты жалуются на умеренные боли в костях, отечность над очагом поражения. Значимые клинические проявления наблюдаются при увеличении опухоли в размерах и уменьшении прочности кости. Возможны патологические переломы, которые возникают при минимальном механическом повреждении конечности либо вовсе не связаны с травмой.
Для эозинофильной гранулемы типично поражение костей верхней и нижней челюсти. При такой локализации очага возможно расшатывание и выпадение зубов у пациентов молодого возраста, патологические переломы челюсти, сложности при проведении стоматологических манипуляций. Изредка болезнь протекает по типу мультисистемного поражения, когда в процесс вовлекаются другие органы. Гистиоцитоз может затрагивать печень, селезенку, кроветворную систему
Болезнь характеризуется полиморфными кожными высыпаниями. Они располагаются на любом участке тела, в том числе на волосистой части головы и в области гениталий. Сначала возникают красные пятна и шелушащиеся бляшки, которые постепенно превращаются в выступающие опухолевидные образования. Узлы приобретают синюшно-багровый цвет, достигают 3-4 см в размерах. На слизистых оболочках ротовой полости и половых органов образуются длительно не заживающие язвы.
Осложнения
Локализованная форма гистиоцитоза отличается благоприятным доброкачественным течением. Основной проблемой считается нарушение целостности костных структур: патологические переломы, возникающие в юном возрасте, нарушают нормальную анатомию и функциональную способность конечности. Для купирования хронических костных болей пациенты могут использовать нестероидные противовоспалительные, бесконтрольный прием которых вызывает НПВП-гастропатию.
При расположении эозинофильной гранулемы в височной кости возможна частична обструкция слухового прохода, которая способствует рецидивирующему наружному отиту. Если очаг расположен вблизи глазницы, развивается экзофтальм и нарушения зрения различной степени тяжести. Поражение позвонков, особенно у детей, чревато нарушениями осанки и стойкой деформаций позвоночного столба.
Диагностика
При клинических признаках эозинофильной гранулемы пациенты чаще всего обращаются к дерматологу или ортопеду-травматологу, после чего получают направление на консультацию онкогематолога. На первом этапе диагностики проводится осмотр кожи и видимых слизистых оболочек, пальпация зон болезненности, выяснение условий и давности появления симптомов. Для подтверждения диагноза назначаются следующие методы исследования:
- Рентгенография костей. При рентгенологическом исследовании определяются единичные или множественные опухолевидные образования, участки деструкции, которые могут располагаться как в трубчатых, так и в плоских костях. При подозрении на эозинофильную гранулему обязательно проводят рентгенографию челюстей.
- УЗИ органов живота. Исследование назначается при подозрении на многоочаговую форму гистиоцитоза, которая протекает с поражением внутренних органов. В таком случае при диагностике обнаруживаются объемные новообразования с неоднородной эхоструктурой в печени, селезенке, внутрибрюшных лимфоузлах.
- Гистологический анализ. Для эозинофильной гранулемы характерны инфильтраты из крупных овальных клеток, которые имеют ядра неправильной формы и большое количество цитоплазмы. При иммуногистохимии подтверждается наличие клеток Лангерганса, большого количества эозинофилов, ограниченного числа лимфоцитов и нейтрофилов.
- Анализы крови. В периферической крови у большинства пациентов обнаруживают гипохромную анемию с анизоцитозом и пойкилоцитозом. Реже встречается нейтрофилез со сдвигом влево, моноцитоз, тромбоцитопения. При выполнении коагулограммы обнаруживают повышение свертывающей способности крови.
- Анализ на онкомаркеры. Для исключения рака костей пациентам проводят исследование крови на тартрат-резистентную кислую фосфатазу. Рост уровня этого маркера является достоверным признаком повышения активности остеокластов и развития пролиферативного процесса.
- Анализ генаBRAF. Молекулярно-генетический метод исследования проводится ля уточняющей диагностики гистиоцитоза. Выявление генной мутации в клетках гранулемы помогает подтвердить диагноз, наличие такой же аномалии в периферической крови требуется для установления группы риска пациента с гистиоцитозом.
Дифференциальная диагностика
Для постановки диагноза необходимо дифференцировать заболевание с другими причинами появления объемных новообразований костей. В процессе обследования исключают онкопатологию:
- остеогенный рак;
- саркому;
- лимфому;
- миеломную болезнь.
При выраженных болях и припухлости проводится дифференциальная диагностика с остеомиелитом. Кожные проявления требуют дифференцировки с синдромом Папийона-Лефевра.
Лечение эозинофильной гранулемы
Хирургическое лечение
При солитарных очагах в костной ткани основным методом терапии является кюретаж с последующим восстановлением целостности кости. В связи с онкологической настороженностью зачастую проводится широкая резекция эозинофильной гранулемы, которая обеспечивает полную ликвидацию новообразования, однако имеет нежелательный функциональный результат. После такой операции потребуется костная пластика для замещения ятрогенного дефекта.
Консервативная терапия
Фармакотерапия и облучение оправданы при множественной гранулеме, вовлечении в патологический процесс кожи и внутренних органов. Общепринятые протоколы терапии отсутствуют, поэтому программа подбирается индивидуально с учетом особенностей заболевания у конкретного больного. Медикаментозная терапия включает цитостатики, которые применяются для замедления пролиферации клеток, и глюкокортикоиды, стимулирующие репарацию после кюретажа.
Локализация гранулем в костях конечностей и черепа открывает широкие возможности лучевой терапии. Облучение проводится как альтернатива хирургическому вмешательству, если новообразование недоступен для кюретажа, либо пациент имеет противопоказания к оперативному лечению. После радиотерапии полная ремиссия наблюдается у 85% пациентов, причем контроль над солитарным очагом болезни удается получить в 95% случаев.
Важное место в терапевтической программе занимает лечение кожных очагов гистиоцитоза. Терапевтическая программа подбирается только после гистологического исследования биоптатов. Пациентам показана системная терапия, которая включает препараты альфа-интерферона, метотрексата и леналидомида. Они обладают противовоспалительными, антиангиогенными и иммуномодулирующими свойствами.
Прогноз и профилактика
Солитарная эозинофильная гранулема признана наиболее доброкачественной формой гистиоцитоза. Более благоприятный прогноз для больных с изолированными местными проявлениями и отсутствием системных осложнений болезни. Многоочаговый вариант гистиоцитоза протекает менее благоприятно. Точные причины и механизм развития заболевания пока не ясны, поэтому эффективные меры профилактики отсутствуют.
1. 1. Гистиоцитоз из клеток Лангерганса у взрослых: современные возможности терапии/ В.Д. Латышев, Е.А. Лукина// Клиническая онкогематология. - 2021. - №14.
2. 2. Гистиоцитоз из клеток Лангерганса (гистиоцитоз Х): клиническое наблюдение/ И.А. Горланов/ Вестник дерматологии и венерологии. - 2013. - №1.
4. Доброкачественное течение гистиоцитоза Х/ Шихнебиев Д.А., Эседов Э.М., Джалилова Л.М.// Клиническая медицина. - 2002 - №7.
Диагностика саркоидоза — болезни Бенье-Бека-Шаумана

Разработчик сайтов, журналист, редактор, дизайнер, программист, копирайтер. Стаж работы — 25 лет. Область интересов: новейшие технологии в медицине, медицинский web-контент, профессиональное фото, видео, web-дизайн. Цели: максимально амбициозные.
- Запись опубликована: 16.06.2022
- Reading time: 4 минут чтения
Полная диагностика этого заболевания проводится в условиях стационара. В первую очередь назначаются визуальные тесты легких. Особенно полезен рентген грудной клетки.
Причины трудностей при диагностике саркоидоза: мультиорганная локализация, разнообразная клиническая картина и течение. Дифференциация включает системные воспалительные заболевания соединительной ткани, бактериальные и вирусные инфекции.
Чтобы подтвердить диагноз, требуются морфологические тесты, позволяющие провести сбор тканей для визуализации в них характерных эпителиоидно-клеточных гранулем. Таким обследованием может быть бронхоскопия, то есть введение эндоскопа через ротовую полость в дыхательную систему. Это дает возможность взять пробы из лимфатических узлов.
В зависимости от течения и длительности заболевания, а также от того, какие органы поражены гранулемами, могут потребоваться другие дополнительные анализы.
Сбор анамнеза и физикальное обследование при саркоидозе
Сбор анамнеза подразумевает выявление жалоб и факторов, располагающих к развитию патологии.
Физикальное обследование включает:
- осмотр тела на наличие очагов на коже;
- аускультацию (выслушивание) легких для выявления хрипов, шумов, нарушений сердечного ритма и определения частоты дыхания;
- перкуссию (простукивание);
- пальпацию для выявления лимфатических узлов и подкожных очагов.
Рентгенологические методы
Больным проводится обзорная рентгенограмма в 2-х проекциях и КТ грудной клетки. Наиболее информативна мультиспиральная КТ, показывающая даже мельчайшие изменения в легких.
Функциональная диагностика
Больным раз в квартал проводят спирометрию. В стадии ремиссии спирометрию делают раз в год. Второй важный тест выявляет диффузионную способность лёгких.
Бронхоскопия и биопсия при саркоидозе — особенности, расшифровка
На практике, наиболее распространенный метод получения материала для анализа — бронхоскопия. Макроскопические изменения можно обнаружить уже во время обследования. При саркоидозе, например, видны:
- мелкие тонкие сосуды;
- плоские желтые диски на слизистой оболочке бронхов;
- небольшие кремовые или желтые узелки.
При макроскопически правильной визуализации бронхов диагноз можно поставить половине пациентов, а при наличии четких поражений результативность достигает 90%.
Также пациентам проводится трансбронхиальная биопсия легкого, если нет противопоказаний. Это обследование информативно даже на 1 стадии, когда визуализирующие методы не показывают изменения паренхимы легких. При гистопатологическом исследовании кокки обнаруживаются у 80% больных.
При биопсии рекомендуется брать до 5 проб. Процедура достаточно безопасная. Возможные осложнения — пневмоторакс и кровотечение. Чувствительность биопсии достигает 90%. Выполнение биопсии сразу с двух отделов — слизистой оболочки бронхов и легких увеличивает шанс диагностики на 20%.
Другие доступные процедура при бронхоскопии — трансбронхиальная, чреспищеводная игольчатая аспирация. Благодаря развитию эндоскопических ультразвуковых методов, эндобронхиальной ультрасонографии и чреспищеводному УЗИ, количество точных диагнозов, поставленных с помощью этого метода, достигает 85%. Существенных осложнений у этой процедуры также нет.
Больных без гистопатологического подтверждения с помощью бронхоскопических методов, направляют к торакальным хирургам на медиастиноскопию или биопсию легких с помощью видеоторакоскопии. В случае синдрома Лефгрена гистология не требуется.
Без гистопатологического подтверждения вероятность правильного диагноза, основанного на клинической и рентгенологической картине:
- I стадия — 98%;
- II стадия — 89%;
- III стадия — 52%;
- IV стадия — 23%.
Ученые предлагают разные методы уточнения диагноза. Например, можно при бронхоскопии оценить индекс лимфоцитов Cd4 + / Cd8 + и активность ангиотензинпревращающего фермента, хотя и считается, что АПФ имеет ограниченную диагностическую ценность и полезен в основном для наблюдения за течением болезни.
Клеточный состав, полученный при лечебной бронхоскопии, не патогномоничен для саркоидоза. Общее количество клеток может быть нормальным или несколько увеличенным. Обычно процентное содержание эозинофилов и нейтрофилов в норме. У большинства больных в жидкости бронхоальвеолярного лаважа отмечается лимфоцитоз, но и нормальное количество лимфоцитов не исключает патологии.
Наибольшее значение в диагностике саркоидоза имеет размер индекса лимфоцитов Cd4+ / Cd8+. Условие оценки индекса лимфоцитов Cd4+ / Cd8+ — наличие не менее 15% лимфоцитов в жидкости. Индекс лимфоцитов Cd4+ / Cd8+ > 3.5 характеризуется низкой чувствительностью, но высокой специфичностью для саркоидоза, достигающей значения 96%.
Клиническое значение бронхоскопии также имеет ограничения. Например, лимфоцитоз может обнаруживаться и при аллергическом альвеолите, неспецифической интерстициальной пневмонии, лимфоцитарной пневмонии. В 15% случаев количество лимфоцитов находится в пределах нормы.
Лабораторная диагностика саркоидоза
Диагноз основывается на клинической картине и гистопатологическом проявлении гранулем в пораженных органах. Что касается лабораторной диагностики, то надежного теста для подтверждения саркоидоза до сих пор не существует. Также не подтверждает однозначно диагноз саркоидоз наличие гранулем только в одном органе, поэтому сначала обязательно исключают другие заболевания, связанные с образованием саркоидоподобной грануляционной ткани.
Врач может назначить:
- Общий анализ крови. Изучаются лейкоциты, эритроциты, тромбоциты, гемоглобин. Анализ крови может быть нормальным. Возможные нарушения: низкие лимфоциты, высокая СОЭ и повышенные лейкоциты.
- Общий анализ мочи. Изучаются: плотность, белок, глюкоза, цилиндры, наличие бактерий.
- Туберкулиновые пробы. Чтобы исключить туберкулёз.
- Биохимия крови. Изучаются: кальций, печёночные ферменты, креатинин, мочевина, АПФ. Могут указывать на активность заболевания повышенные концентрации АПФ выше 35 Ед/л у детей и более 50 Ед/л у взрослых. Но повышенное содержание АПФ в сыворотке крови может наблюдаться при других патологиях — болезни Гоше, бериллиозе, лепре, силикозе, асбестозе, пневмокониозе.
Повышенные уровни АПФ в сыворотке также обнаруживаются при гипертиреозе, диабете, циррозе печени, туберкулезе, ВИЧ-инфекции и аллергическом альвеолите. Поэтому чувствительность этого исследования оценивается в 57%, а специфичность — в 90%. Повлиять на результаты могут: системные глюкокортикостероиды и ингибиторы АПФ, поэтому их прием прекращают за 3 суток до анализа.
Для диагностики саркоидоза ранее проводились анализы на биомаркеры в сыворотке крови и в бронхоальвеолярном лаваже: лизоцим, β-2 микроглобулин, аденозиндезаминаза, неоптерин, белок острой фазы (hsCRP), TNF-α, рецептор IL-2, проколлаген III, хемотаксический белок моноцитов, макрофагальный воспалительный белок-1 альфа (MIP-1α). Но из-за низкой чувствительности и специфичности эти маркеры в настоящее время не используются.
Предпринимаются попытки диагностировать саркоидоз путем определения популяции клеток-предшественников (CD34+) и проведения теста высвобождения интерферона-IGRA для дифференциации легочного саркоидоза от туберкулеза.
Диагностика, подтверждающая необходимость терапии
После постановки диагноза следует оценить степень саркоидоза и показания к терапии. Выполняются:
- ;
- морфологический анализ и тесты на трансаминазы, билирубин, креатинин, уровни кальция, активность ангиотензин-превращающего фермента сыворотки (АПФ);
- анализ на кальций в суточной моче; и эхокардиография;
- офтальмологическое обследование в щелевой лампе.
Подсчет лимфоцитов бесполезен при определении необходимости терапии саркоидоза.
Функцию легких оценивают с помощью плетизмографии (колебания объема, связанное с кровенаполнением сосудов), оценки D LCO (диффузионной емкости легких для окиси углерода) и теста 6-минутной ходьбы. У каждого пятого больного гиперреактивность бронхов связана с наличием гранулем на слизистой оболочке этих органов. У 60% — изменения носят ограничительный характер с сопутствующим снижением D LCO.
В зависимости от клинического состояния некоторым больным требуется расширенная диагностика. При симптомах со стороны ЦНС проводят МРТ головы. В случае изменений эхокардиографии сердца или наличия клиники со стороны системы кровообращения нужны холтеровская электрокардиография и МРТ сердца.
Дифференциальная диагностика
Саркоидоз дифференцируют от следующих заболеваний:
- ;
- микобактериоз; ; ;
- гистоплазмоз;
- бластомикоз;
- пневмоцистоз;
- аллергическая пневмония;
- пневмокониоз; ;
- синдром Черджа-Стросса;
- лимфоидная интерстициальная пневмония.
Подобные изменения возможны при наличии инородного тела в бронхах, реакции на лекарства и гистиоцитозе клеток Лангерганса.
Саркоидная реакция в регионарных лимфатических узлах при раке и гранулематозные поражения неизвестного значения занимают до 20% всех случаев гранулем лимфоузлов. Патоморфологические исследования обнаруживают вокруг таких гранулем преимущественно В-лимфоциты, а при саркоидозе — Т-лимфоциты. Также поражения лимфатических узлов при саркоидозе необходимо дифференцировать от туберкулеза, бруцеллеза, токсоплазмоза, болезни кошачьих царапин (фелиноз) и лимфом.
Клинические симптомы саркоидоза обычно неспецифичны:
- — у половины больных;
- непереносимость физической нагрузки — 95%;
- миалгия — 29%;
- офтальмологические проблемы — 25%. — 32%.
Кашель, боль в груди, артралгия и потеря веса при саркоидозе отмечаются реже, чем при других патологиях.
Дифференциальная диагностика гистиоцитоза Х
Описан случай гистиоцитоза X у пациентки 25 лет. Особенностью явилось развитие болезни в возрасте 20 лет, преимущественное поражение кожных покровов и незначительно выраженные другие симптомы. Подчеркнута необходимость повторных гистологических исследований у таких пациентов.
The Case of Histiocytosis from Langerhans cells
A case of histiocytosis X in a patient of 25 years was described. Feature was the development of the disease at the age of 20 years, mainly affecting the skin and slightly expressed in other symptoms. Stressed the need for repeated histological studies in such patients.
Гистиоцитоз из клеток Лангерганса (прежние термины: гистиоцитоз Х, болезнь Хенда — Шюллера — Крисчена, эозинофильная гранулема, болезнь Таратынова, болезнь Леттерера — Сиве) — исключительно разнообразное по клиническим проявлениям и течению заболевание, характеризующееся накоплением и/или пролиферацией в очагах поражения клеток с характеристиками эпидермальных гистиоцитов — клеток Лангерганса [1].
В начале 20-го века различные варианты этого заболевания были охарактеризованы как самостоятельные нозологические формы. В 1953 г. L. Lichtenstein объединил ранее описанные варианты под общим названием «Гистиоцитоз Х». В 1973 г. С. Nezelof с соавт. идентифицировал гистиоциты из очагов поражения как клетки, несущие структурно-функциональные маркеры эпидермальных клеток Лангерганса. В 1987 г. историческое название «Гистиоцитоз Х» было предложено заменить термином «Гистиоцитоз из клеток Лангерганса», так как последний отражает гистогенетическое происхождение клеток, составляющих морфологическую и патофизиологическую основу данного заболевания.
Гистиоцитоз из клеток Лангерганса (ГКЛ) — редкое заболевание, в детском возрасте встречается с частотой 3-4 случая на 1 миллион детского населения в год, у взрослых еще реже, с частотой, не превышающей 1: 560 000 взрослых [5].
Выделяют моносистемную (поражение одного органа или системы органов) и полисистемную (поражение двух и более органов или систем органов) формы заболевания. Моносистемное заболевание может протекать с одним очагом поражения (одноочаговые) или двумя и более очагами (многоочаговые), с нарушением и без нарушения функции жизненно важных органов [3].
Клиническая симптоматика и исходы ГКЛ варьируют от спонтанно излечивающихся одиночных очагов поражений до быстро прогрессирующих диссеминированных форм, приводящих к полиорганной недостаточности. Наиболее часто встречаются одиночные или множественные поражения костей, преимущественно свода черепа, голеней, ребер, таза, позвонков, нижней челюсти. Характерным проявлением ГКЛ служит развитие несахарного диабета, который изредка сочетается с дисфункцией передней доли гипофиза или гипоталамической дисфункцией (ожирение, аменорея). В 30-40% случаев встречаются поражения кожи: дерматозы папулодесквамозного, себорейного, экзематозного и реже ксантоматозного типов. Лимфатические узлы поражаются у детей в 20-30% случаев, у взрослых значительно реже (4%). Поражение легких является редким (2%) начальным и частым (60%) поздним, прогностически неблагоприятным симптомом у детей. Напротив, у 50-60% взрослых больных ГКЛ наблюдается изолированное поражение легких, которое протекает бессимптомно и выявляется при случайных рентгенологических исследованиях в виде очаговой диссеминации на фоне усиленного и сетчато-тяжистого легочного рисунка. Высокая лихорадка, гепатоспленомегалия и цитопения нехарактерны для взрослых, больных ГКЛ, но встречаются у детей при диссеминированных формах заболевания, характеризующихся крайне неблагоприятным прогнозом [2, 4].
Учитывая длительное течение заболевания, наличие обширных эрозивных поверхностей кожи в себорейных зонах, неэффективность проводимой терапии, был выставлен диагноз «себорейная пузырчатка»? Отсутствие в мазках-отпечатках клеток Тцанка предположительно можно было объяснить особенностями данной формы пузырчатки и достаточно длительным приемом небольших доз преднизолона. Учитывая несоответствие клинической картины заболевания и лабораторных данных, была рекомендована биопсия кожи из очагов поражения.
Исследование № 66/10 проведено в гистологической лаборатории Казанского республиканского кожно-венерологического диспансера с использованием диагностической экспертной системы «Гистодерм® v1,0». Описание микропрепарата: очаговый ортокератоз, очаговый паракератоз, спонгиоз и внутриклеточный отек шиповатого и базального слоев, очаговая вакуольная дистрофия эпидермоцитов, встречаются деформированные эпидермоциты с уродливыми и фрагментированными ядрами. В дерме очагово-сливной инфильтрат, состоящий преимущественно из мононуклеарных лейкоцитов, с наличием полигональных крупных клеток, двуядерных и многоядерных клеток. Аналогичная инфильтрация в стенках артериол и капилляров. Отек коллагена дермы. Заключение: хронический дерматит с очаговой дисплазией эпидермиса. Примечание: данная морфологическая картина характерна для многих хронических дерматозов под воздействием длительного лечения иммуносупрессивными препаратами. Для установления нозологической формы рекомендуется отмена кортикостероидных препаратов и проведение повторной биопсии кожи.
Пациентке было проведено следующее лечение: Ацесоль 400,0 в/в капельно № 3, Дисоль 400 в/в капельно № 2, Альбумин 10% — 100,0 в/в капельно № 3, Преднизолон (пульс-терапия по 300 мг в/в капельно № 3, Преднизолон в дозе 80 мг в сутки с постепенным снижением до 30 мг в сутки), Метотрексат в дозе 20 мг в/м 1 раз в неделю № 5, препараты калия, ферментные препараты, антибактериальная терапия, седативная терапия, наружная терапия: туширование 1%-ным водным раствором метиленового синего, аэрозоль «Полькортолон», мази «Гиоксизон», «Эритромициновая», «Адвантан», «Акридерм».
После проведенного лечения эрозии подсохли и часть их оставалась покрытой корками. Такое состояние сохранялось в течение 3 месяцев, несмотря на продолжающуюся терапию кортикостероидами.
Учитывая отсутствие дальнейшей положительной динамики процесса на фоне комплексной терапии, рекомендовано направление на консультацию и коррекцию лечения в ФГУ «ГНЦД Росмедтехнологий», где больная находилась в отделении клинической дерматологии с 28.10.2010 по 22.11.2010. Наряду с клиническим обследованием проведено гистологическое исследование. B препаратах биоптаты кожи, полученные с правой височной области, зоны декольте и правой молочной железы, в которых патологические изменения носят однонаправленный характер: эпидермис атрофичен, слабый кератоз. В углублениях эпидермиса и расширенных устьях волосяных фолликулов рыхлые роговые пробки. Слои эпидермиса дифференцированы, признаков дискератоза, акантолиза, формирования щелей и пузырей не обнаружено. Субэпидермально обнаруживаются густые сливающиеся инфильтраты из гистиоцитов, лимфоцитов, плазматических клеток. Просветы сосудов расширены. Заключение: признаков себорейной пузырчатки, фолликулярного дискератоза Дарье, красной волчанки не обнаружено. Для исключения диагноза гистиоцитоза будет проведено ИГХ-исследование.
На парафиновых срезах проведена ИГХ-реакция с использованием моноклональных антител к CDla, CD68 и CD3 по стандартной методике с предварительной
демаскировкой в СВЧ. Установлено преобладание CDla+ клеток Лангерганса в составе инфильтрата, которые локализовались преимущественно субэпидермально. CD68 гистиоциты составляют около 50% клеток инфильтрата, равномерно распределены в составе инфильтрата. CD3+ лимфоциты составляют около 40% клеток инфильтрата, локализуются преимущественно в нижней части инфильтрата. Заключение: выявленные изменения характерны для гистиоцитоза X.
Пациентке было проведено следующее лечение с положительным эффектом: Проспидин 50 мг в/м № 2 и 100 мг № 15, Преднизолон 20 мг в сутки, Амоксиклав 1000 мг, 1 табл. 2 раза в день в теч 2 недель, Карсил 1 драже 3 раза в день, Кестин 1 табл. 2 раза в день, Беллатаминал ½ табл. 2 в день 6 дней, Трентал 1 табл. 2 раза в день, Кальций-ДЗ Никомед 1 табл. 2 раза в день (с 25.10.2010 по 28.10.2010), Эссенциале-Н по 1 кап. в день, наружная терапия: лосьон Белосалик, 2%-ный салициловый крем, раствор Фукорцина, крем Фуцидин Г, аэрозоль Скин-кап, аэрозоль Полькортолон, Метиленовый синий, раствор Куриозин, раствор Мирамистин, раствор Фуцидин, раствор Цитеал, крем Адвантан, аэрозоль Олазоль, крем АСД 5%, мазь АСД 5%; паста АСД 5%; мазь Адвантан, мазь Белосалик, мазь Фуцидин. Выписана с улучшением.
В декабре 2010 года в связи с обострением заболевания проведено лечение проспидином в дневном отделении ГМУ РККВД г. Казани.
Данное наблюдение интересно тем, что гистиоцитоз в клинической практике врача дерматолога встречается достаточно редко. Следует отметить позднее начало заболевания и малую выраженность клинических симптомов у пациентки. Целесообразно еще раз подчеркнуть, что для своевременной диагностики гистологическое исследование при всех медленно развивающихся клинически неясных дерматозах должно быть правилом. Если его результаты в комплексе с клиническими проявлениями диагноз не уточняют, за больным следует установить динамическое наблюдение с повторными гистологическими исследованиями кожи до тех пор, пока диагноз не будет подтвержден окончательно.
В.Ю. Дядькин, Р.М. Абдрахманов
Казанский государственный медицинский университет
Дядькин Владимир Юрьевич — кандидат медицинских наук, доцент кафедры дерматовенерологии
Литература:
1. Иванов О.Л. Кожные и венерические болезни. — М.: Шико, 2002. — 478 с.
2. Карр Я. и др. Лимфоретикулярные болезни, пер. с англ. — М., 1980. — С. 174.
3. Казаков Д.В., Кемпф В., Самцов А.В., Бург Г. Злокачественные опухоли лимфоидной ткани с поражением кожи: современные принципы диагностики и краткая характеристика основных нозологических форм. Вестн. дерматол. венерол., 2002; 1; 23-33.
4. Наследственные и приобретенные болезни крови у детей / под ред. Н.С. Кисляк. — М., 1980. — С. 131.
5. Фицпатрик Т. Дерматология, атлас-справочник. — М.: Практика, 1999. — 1044 с.
Гистиоцитоз Х
Лангерганс-клеточный гистиоцитоз лёгких (гистиоцитоз легких) относится к редким формам заболеваний, характеризующихся пролиферацией в органах и тканях клеток Лангерганса. В зависимости от преимущественной локализации (кожа, костная ткань, легкие, печень, гипофиз, лимфатические узлы) изменений выделяют несколько вариантов гранулематоза из клеток Лангерганса (Летерера-Сиве; Хенда-Шюллера-Крисчена; локальная эозинофильная гранулема).
Представления о гистиоцитозе X как самостоятельной нозологической форме начали формироваться в 1921 г., когда A. Hand обобщил свои наблюдения и наблюдения A. Schuller и Н.А. Christian больных с гепатоспленомегалией, лимфаденопатией, очаговыми поражениями костей с полиурией и экзофтальмом. Локализованный вариант гистиоцитоза, характеризующийся образованием гранулём из клеток Лангерганса в костях, был впервые описан в 1913 г. Н.И. Таратыновым. Заболевание часто протекает бессимптомно. Разрушение костной ткани может приводить к часто рецидивирующим переломам. В 1953 г. L. Lichtenstein объединил все наблюдавшиеся варианты в одно заболевание, предложив термин «гистиоцитоз X».
Эпидемиология и этиология
Гистиоцитоз чаще встречается у лиц молодого и среднего возраста. Распространённость у мужчин составляет 0,27 на 100 000 населения; у женщин это заболевание встречается в 4 раза реже. В основе патогенеза лежат разнообразные изменения клеток иммунной системы. Подавляющее большинство больных гистиоцитозом X — злостные курильщики. Среди пациентов, страдающих изолированным Лангерганс-клеточным гистиоцитозом лёгких, курящие составляют 96,5%. Большее значение имеет не стаж курения, а количество сигарет, выкуриваемых за сутки.
Клиническая картина
Начало заболевания обычно отмечается в возрасте 20-40 лет. Ведущими признаками являются сочетание респираторных (легочных) симптомов с лихорадкой и потерей веса, спонтанными пневмотораксами, диффузными инфильтративными изменениями на рентгенограммах. Симптомы заболевания могут быть представлены в различной степени. В 15% случаев заболевание протекает стёрто. У большинства (до 70%) больных наблюдается непродуктивный кашель, одышка (в 40%). Кроме того характерны боли в грудной клетке, в том числе вследствие поражения плевры (в 20%). Треть пациентов предъявляет жалобы на выраженную слабость, потерю массы тела, лихорадку. Поражение лёгких сочетается с изменениями в других органах, включая гипоталамус и гипофиз, что приводит к развитию несахарного диабета; наблюдаются поражения опорно-двигательного аппарата в виде участков деструкции костной ткани; изменений на коже; отмечаются шейная лимфаденопатия; увеличение щитовидной железы; гепатоспленомегалия.
Осложнения
Наиболее высок риск пневмоторакса. Спонтанный пневмоторакс считается типичным проявлением гистиоцитоза и регистрируется у 15-25% больных, у 10-15% он наблюдается уже в начале болезни, а у 20-25% спонтанный пневмоторакс и плевральные боли рецидивируют на всём протяжении болезни. Кровохарканье встречается у 13% больных. Лёгочная гипертензия также является одним из наиболее частых осложнений.
Инструментальная диагностика
КТ (МСКТ) и биопсия лёгкого являются обязательной частью обследования больных с подозрением на гистиоцитоз.
- Рентгенографические изменения в лёгких неспецифичны.
- КТ (МСКТ) позволяет с большей вероятностью подтвердить диагноз и даже выделить признаки, имеющие дифференциально диагностическое значение.
- Для выявления внелёгочных костных поражений используется рентгенография и сцинтиграфия костей. МРТ позволяет подтвердить вовлечение костей и внутренних органов более чем у половины больных, тогда как сцинтиграфия — у 38%, а рентгенологическое исследование — у 25% . Развитие несахарного диабета, проявляющегося выраженными полиурией и полидипсией (сильнейшая жажда), связано с недостаточной секрецией аргинин-вазопрессина вследствие инфильтрации клетками Лангерганса гипоталамических и/или гипофизарных структур. Диагноз подтверждают с помощью МРТ.
- Морфологическое подтверждение диагноза включает выявление клеток Лангерганса в смыве бронхиально-альвеолярного лаважа, а также в участках лёгочной ткани, полученной при биопсии.
- При исследовании функции внешнего дыхания у большинства больных отмечаются рестриктивные изменения со снижением общей ёмкости лёгких и показателей эластичности. Уменьшение диффузионной способности лёгких отмечается у большинства больных и усиливается в условиях нагрузки.
Прогноз и профилактика
Средняя продолжительность болезни достигает 10-12 лет. Причинами смерти становятся дыхательная недостаточность, лёгочная гипертензия, опухоли (гемобластозы, рак лёгкого). Лёгочная гипертензия считается ведущим фактором риска неблагоприятного прогноза. Вовлечение плевры, несахарный диабет также рассматривают как маркёр неблагоприятного прогноза. Своевременный отказ от курения позволяет смягчить течение болезни и является первоочередной задачей.
Читайте также:
